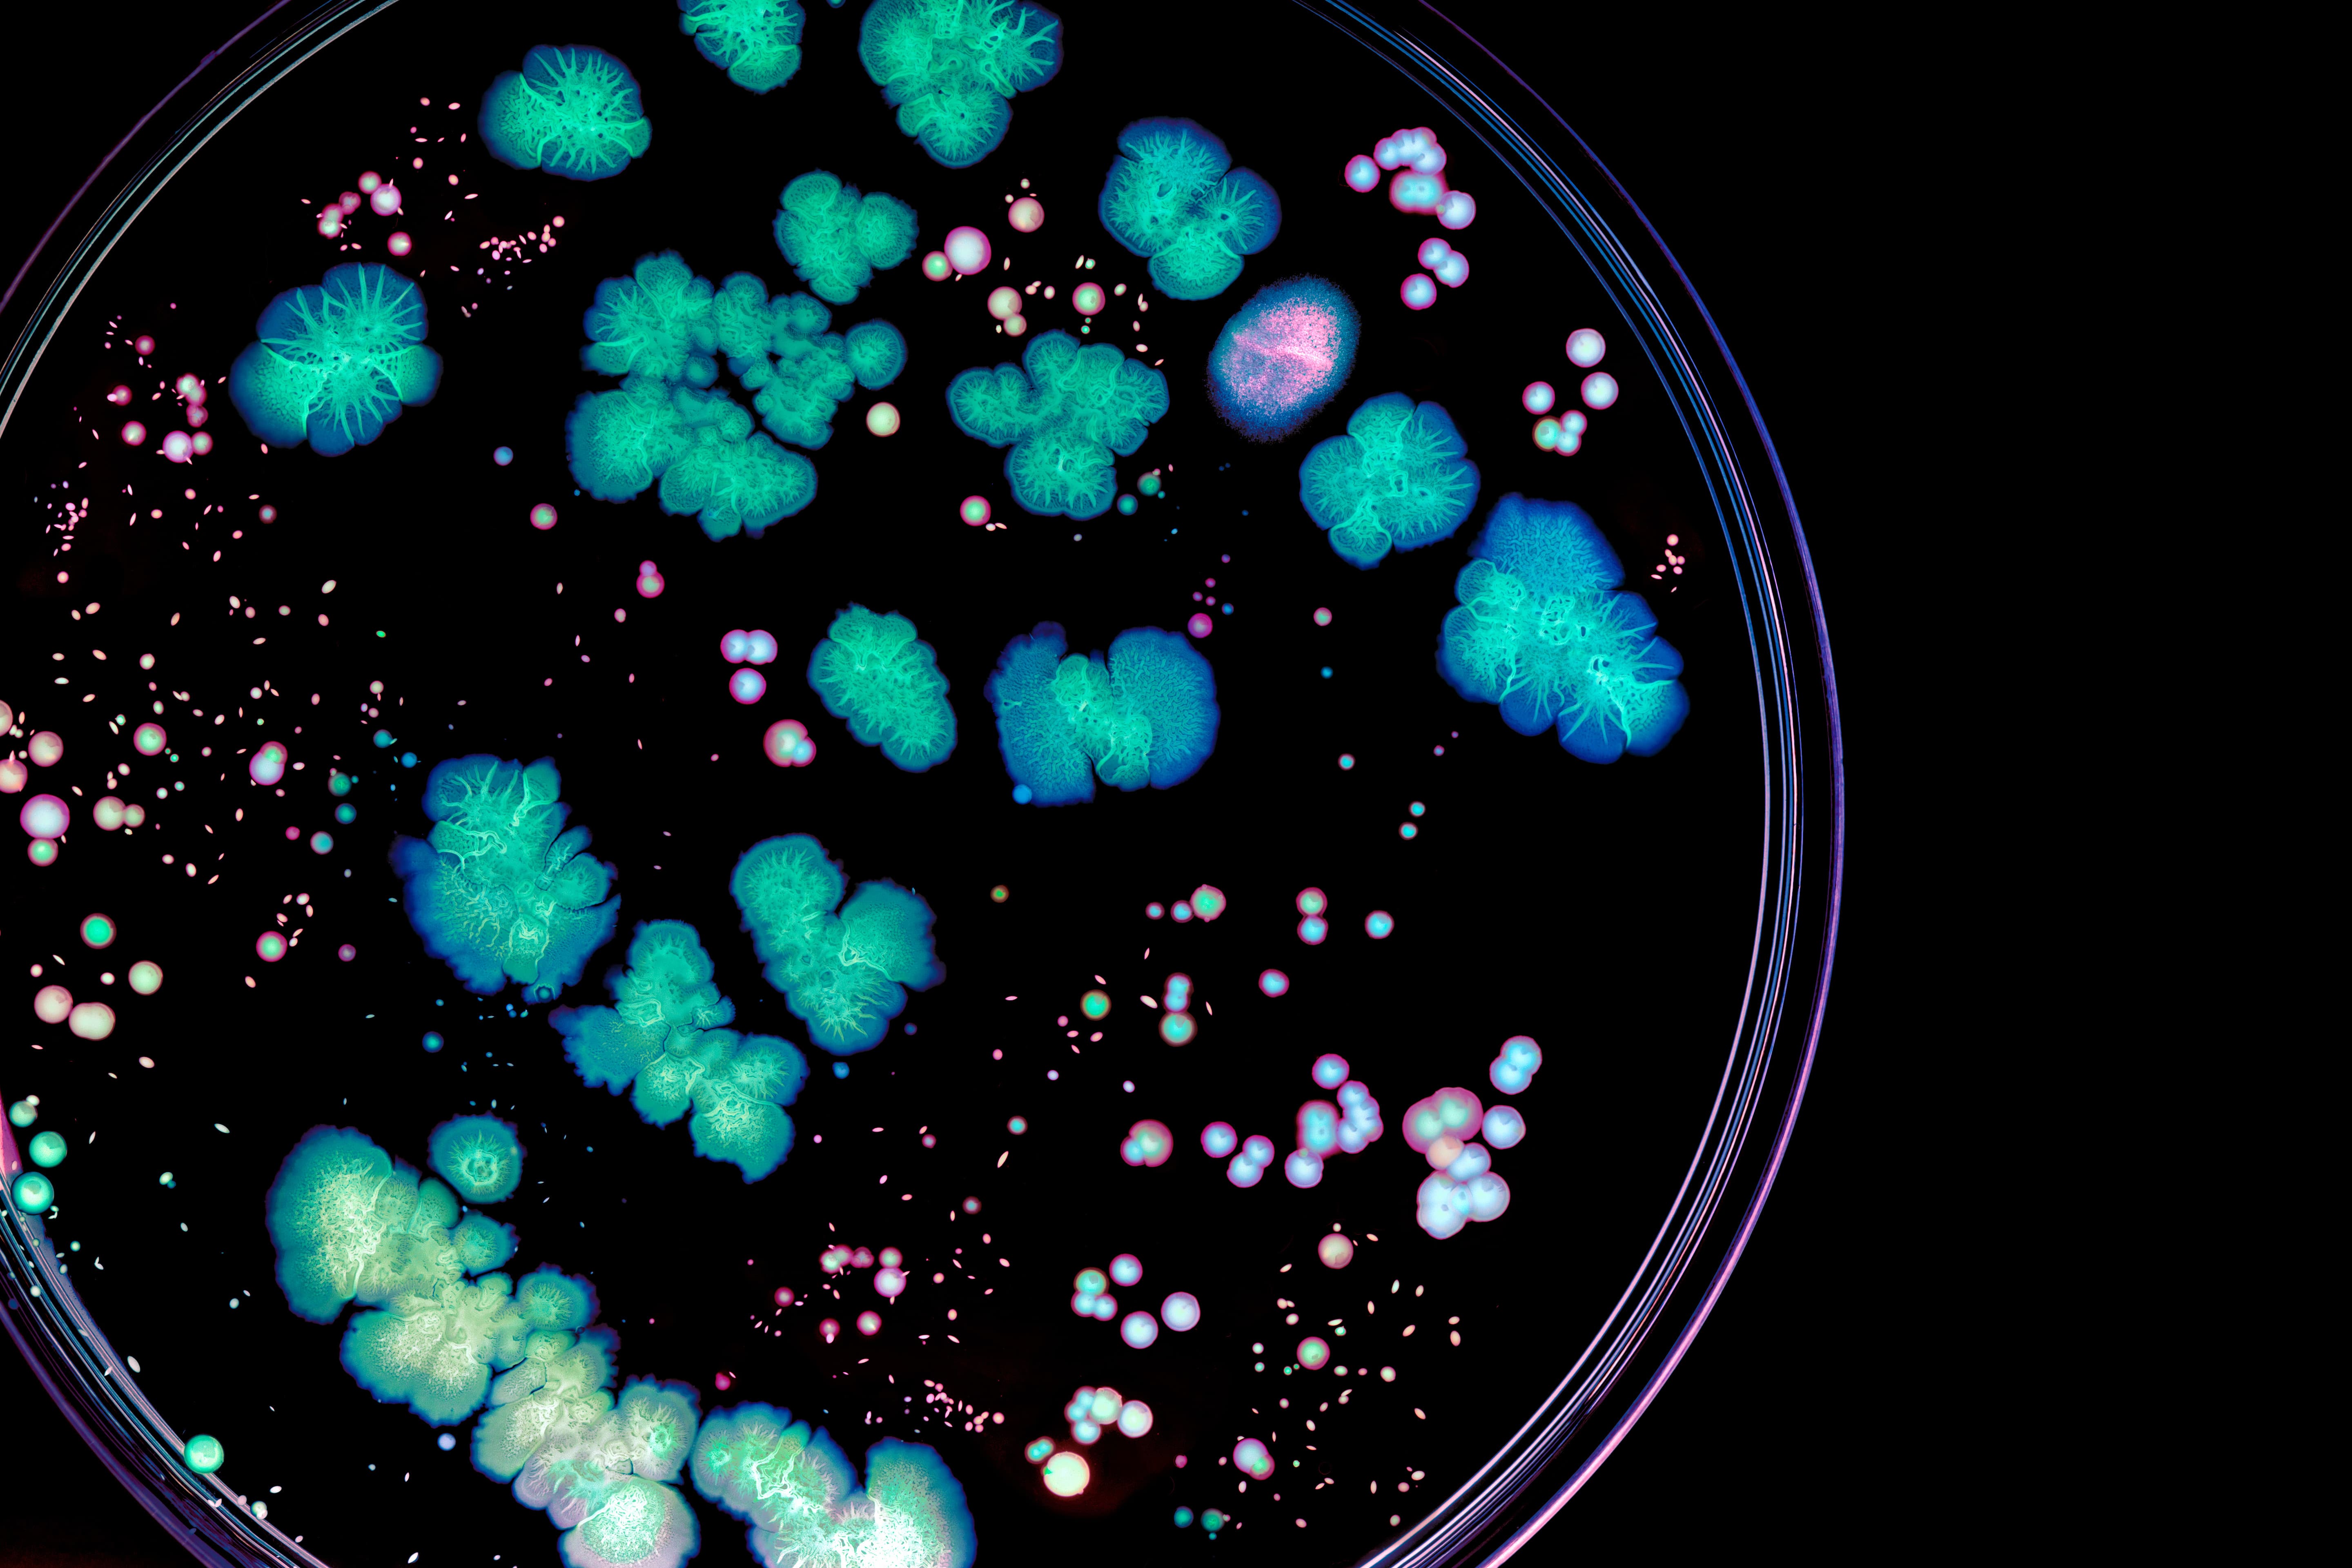
TVC

CTS Water Microbiology provides routine Total Viable Count (TVC) testing to determine the number of bacteria, yeast, or mould species in a water sample. This test is often performed with a test for specified microorganisms, such as E. coli.
What Is Total Viable Count?
Harmful bacteria are removed from water supplies before being piped to homes and businesses to make consumption safe. However, low levels of varying microorganisms can remain in our domestic systems. If these are allowed to breed, it can compromise water quality.
Total Viable Count (TVC), also known as Aerobic Plate Count (APC) or Aerobic Colony Count (ACC), is a measurement that estimates the total amount of viable (having the ability to grow) microorganisms in a water sample. This includes bacteria, yeast, and mould species.
The results from a Total Viable Count test indicate the general level of contamination and potential colony formation within a system.

Our Total Viable Count Testing Services
At CTS Water Microbiology, we carry out professional Total Viable Count testing for various sample types at our certified laboratory.
Depending on the environment being sampled, there are different test parameters we will follow. Drinking water system samples, for example, are incubated at 22°C or 37°C for 24 hours in accordance with BS EN ISO 6222:1999.
- At 22°C, the TVC specifies the number of live bacteria per ml of water at ambient temperature, meaning the count will mostly be composed of harmless bacteria.
- At 37°C, the TVC specifies the number of live bacteria per ml of water at body temperature, meaning the bacteria that grow will be more likely to harm humans.

On the other hand, cooling tower system samples are incubated at 30°C in accordance with HSE ACOP L8 and HSG274. These test conditions are set to isolate the range of microorganisms that can colonise, compromise water quality, and cause infections.
Because Total Viable Count testing can identify many different microorganisms, it is referred to as non-selective. This is unlike testing for specific bacteria, such as Legionella, E. coli, and Pseudomonas.
Why Test for Total Viable Count?
Alongside estimating the level of contamination in a water sample, Total Viable Count testing can be used to recognise abnormal trends in microbial counts, assess why these changes may have occurred, and inform appropriate resolutions to prevent reoccurrence.
For example, a high TVC was identified in multiple commercial buildings across London that had been forced to close for a long period due to COVID-19. This data led to an investigation which showed that the lack of water usage (e.g., lack of toilet flushing) contributed to bacterial growth.
Total Viable Count testing can also be used to examine the efficiency of water treatment regimes. High TVC results in mains-fed water coolers, for instance, may indicate that they are not being cleaned properly or that the frequency of cleaning regimes needs to be increased.

CTS Water Microbiology for Total Viable Count Testing
Businesses have a duty of care to ensure their water systems are adequately protected and safe for users. Through routine Total Viable Count testing, you can assess your water quality, monitor for contaminants, and identify new treatment approaches to tackle issues effectively.
At CTS Water Microbiology, we streamline the water testing process with 24 sample drop-off locations across the UK and Ireland, a dedicated team of drivers, and our accredited laboratory.
Our highly experienced staff ensure samples are handled quickly and securely, delivering accurate results and offering expert assistance with any concerns you may have.

To learn more about our microbiology and chemistry testing services and how we can help you, contact the CTS Water Microbiology team today!